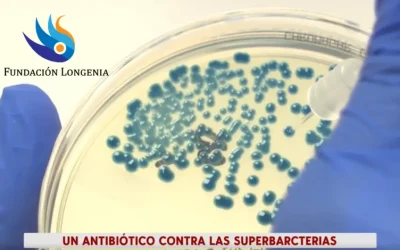
Avances más recientes con la Lariocidina, una nueva clase de antibiótico contra las superbacterias
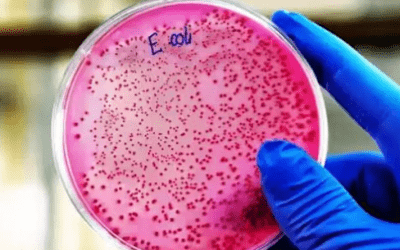
Un posible biomarcador temprano: la colibactina y el cáncer colorrectal en jóvenes

Noticias

Avances más recientes con la Lariocidina, una nueva clase de antibiótico contra las superbacterias
De péptido “lazo” prometedor a candidato clínico: optimización de producción y nuevas estrategias terapéuticas. En marzo de 2025, la revista Nature presentó la lariocidina, un antibiótico lasso-péptido capaz de inhibir el ribosoma bacteriano y derrotar cepas...
Más de 1.000 millones de jóvenes sufrirán problemas de salud en 2030
Un estudio de The Lancet alerta de una crisis global: para 2030, más de la mitad de los 2.000 millones de adolescentes y jóvenes del mundo afrontarán obesidad, trastornos mentales, VIH u otras afecciones.La segunda Comisión sobre Salud y Bienestar de los Adolescentes,...
La brecha de género en la sanidad: un problema que afecta a la salud de las mujeres
La falta de atención adecuada hacia las mujeres en el campo médico es una realidad alarmante. A pesar de los avances en la medicina, las mujeres siguen estando infraestudiadas, infradiagnosticadas e infratratadas. Este problema se agrava aún más en el contexto del...
El 90 % de los ictus y el 40 % de los casos de Alzheimer pueden evitarse
La prevención es la clave para un envejecimiento saludable. Estudios recientes revelan que hasta un 90 % de los ictus y un 40 % de los casos de Alzheimer podrían evitarse si actuamos sobre los factores de riesgo modificables comunes. Principales hallazgos: 17 factores...
¿Puede revertirse el envejecimiento?
El envejecimiento resulta ser un proceso maleable: estudios con los factores Yamanaka (Oct4, Sox2, Klf4 y c‑Myc) han logrado rejuvenecer células diferenciadas sin llegar a su pluripotencia, y en ratones han mejorado parámetros fisiológicos y reducido la edad biológica...
Nanorrobots contra el cáncer: una sola dosis reduce un 90% los tumores de vejiga en ratones
Una innovación del IBEC que podría transformar el tratamiento de uno de los cánceres más persistentes y costosos En un avance revolucionario liderado por el Institut de Bioenginyeria de Catalunya (IBEC) y el CIC biomaGUNE, se ha conseguido reducir el volumen de los...
Ejercicio físico y longevidad
La ciencia de la longevidad avanza a pasos agigantados, y uno de sus máximos exponentes, el Dr. Eric Topol, lo deja claro: el ejercicio es la intervención más poderosa para frenar el envejecimiento. Topol, cardiólogo, fundador del Scripps Research Translational...
CANYA: la IA española que descifra el lenguaje de la agregación de proteínas y allana el camino a nuevos tratamientos
La agregación amiloide, responsable de patologías como el Alzhéimer y más de 50 enfermedades neurodegenerativas, supone un gran reto para la investigación y la industria farmacéutica. Investigadores del IBEC y del CRG han desarrollado CANYA, una herramienta de...
Tiene un premio Nobel y cree que “no estamos programados para morir”: implicaciones para la longevidad humana
Venkatraman Ramakrishnan, Nobel de Química 2009, afirma que la muerte no está programada en nuestros genes, sino que surge como efecto secundario de la evolución centrada en la reproducción. ¿Qué significa esto para la investigación en envejecimiento y para ti? La...
Un posible biomarcador temprano: la colibactina y el cáncer colorrectal en jóvenes
Un estudio internacional liderado por la Universidad de California en San Diego y el CNIO asocia la exposición infantil a la toxina colibactina, producida por cepas de Escherichia coli, con un mayor riesgo de cáncer colorrectal antes de los 40 años. Fundación Longenia...